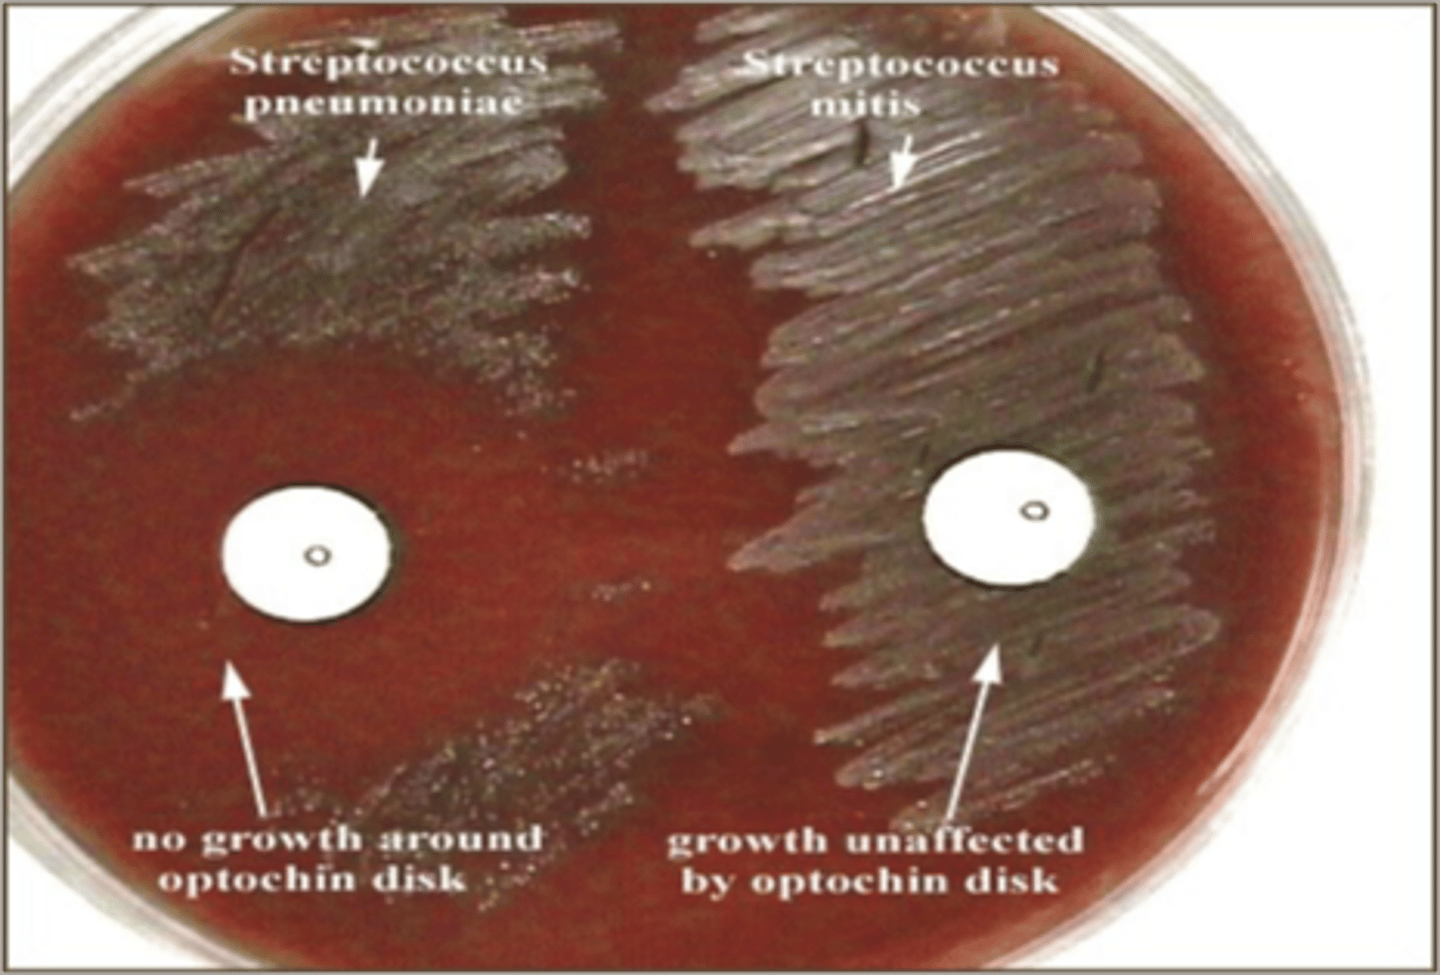
<p>bacitracin</p><p>-8-10 mm = positive</p><p>-sensitive for group A strep species</p>

1/20
Looks like no tags are added yet.
Name | Mastery | Learn | Test | Matching | Spaced | Call with Kai |
|---|
No analytics yet
Send a link to your students to track their progress
Strep pnemoniae cellular arrangement
diplococci
Streptococcus faecalis (Enterococcus faecalis)
Chains or pairs
Streptococcus pyogenes
Long chains
Staphylococcus aureus
clusters
Staphylococcus saprophyticus
Clusters
Staphylococcus epidermidis
clusters
beta hemolysis
Complete hemolysis, giving a clear zone with a clean edge around the colony
alpha hemolysis
partial hemolysis (green)
gamma hemolysis
no hemolysis
bile esculin positive/negative
positive= blackening → hydrolysis of esculin in presence of bile
negative= no darkening

catalase positive/neg
positive=bubbles
negative=no bubbles

coagulase positive/negative
positive= clotting (s.aureus)
negative= no clotting

Mannitol salt agar
selective for salt growing organism differential for mannitol fermenting organisms (s. aureus)
If positive for mannitol fermentation what color will the plate be?
yellow
MAC plates are
selective for gram negative and differential for lactose fermentors (hot pink if ferments lactose)
A discs
bacitracin
-8-10 mm = positive
-sensitive for group A strep species
P discs
-Optochin
-Distinguishes Strep pneumoniae
-10-12 mm

how to perform a catalase test?
hydrogen peroxide drop, loop with bacteria,
bubbles=positive
Direct smear
smear made directly from a clinical sample, not from a culture plate or broth. Example, a smear of asputum sample
State the correlation between the catalase test and cellular arrangement
taphylococci grow in clusters and are catalase positive (bubble with H₂O₂).
Streptococci/Enterococci grow in chains or pairs and are catalase negative (no bubbles).
how to tell if immunoassay is positive for strep Pyogenes ?
pink and blue line (just blue is negative for control)